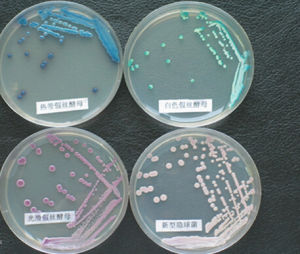
棒狀菌群 棒狀菌群

棒狀菌群
正文
細菌中的 1群。本群細菌革蘭氏染色陽性,無芽孢;形態不規則,有棒狀、桿狀、類球形,有時有原始分枝,但不形成菌絲體。在分類上,棒狀菌群與放線菌比較接近,兩者胞壁組分相似,而棒狀桿菌與放線菌的分枝桿菌屬、諾卡氏菌屬的菌體均含有結構相似的枝菌酸。根據《伯傑氏細菌學鑑定手冊》(第 8版),棒狀菌群包括棒桿菌屬、節桿菌屬、纖維單胞菌屬、短桿菌屬、庫特氏菌屬和微桿菌屬6屬。棒桿菌屬 分為人和動物的寄生菌和致病菌、植物致病菌以及腐生菌 3部分,即①人和動物的寄生菌和致病菌:為直或稍彎曲的桿菌,常呈現棒狀膨大,細胞通過突然折斷分裂形成有角度的和柵狀的排列;一般不運動,不抗酸;碳水化合物的代謝兼有呼吸和發酵兩種方式;胞壁含有消鏇二氨基庚二酸、阿拉伯糖和半乳糖等;為好氧和兼性厭氧菌;DNA中的G+C克分子含量為52%~68%。本部分有9個正式種,模式種為白喉棒狀菌;②植物致病菌:在形態上與人和動物的致病菌相似,但形態變化不那么大,突然折斷分裂一般也沒有那么明顯;有些種能運動;為專性好氧菌;DNA中的G+C克分子含量為65%~75%。本部分有12個種;③腐生菌:已從土壤、水、空氣、染菌的培養基以及血液等樣品中普遍分離到,好氧及兼性厭氧。
本屬內有人畜的致病菌,如白喉棒桿菌引起羊、馬等溫血動物潰瘍性淋巴管炎;也有作物的致病菌,如小麥棒桿菌等。另外,還有在工業上有較大套用價值的菌,如谷氨酸產生菌、粘多糖產生菌、可氧化烴類脫原油蠟質的菌等。
節桿菌屬 在生活史中細胞形態有顯著變化,幼齡菌體完全或大部分是桿狀或不規則桿狀,老細胞則縮短為球形或類球形;呼吸代謝,從不發酵代謝;胞壁不含有消鏇二氨基庚二酸和阿拉伯糖;專性好氧菌。目前正式承認的有 7個種,模式種為球形節桿菌。本屬菌株有的能在甾體化合物的 A環行脫氫作用,因而常被用於製作各種甾體激素藥物,如高效皮質激素(強的松、膚輕鬆、倍他美松等)。
纖維單胞菌屬 幼齡菌體呈不規則的桿狀、直或稍彎,也有棒狀或串珠狀,偶見原始分枝的細胞;老菌體變短,有的成類球狀;本屬的特徵是分解纖維素;胞壁不含有消鏇二氨基庚二酸和阿拉伯糖;好氧或兼性厭氧。模式種為產黃纖維單胞菌。
短桿菌屬 目前對此屬是否成立尚有疑義,因模式種──擴展短桿菌最初被描述為典型短的、不分枝的桿菌,但後來又觀察到它具有節桿菌屬的性狀。從胞壁組分的分析也發現原本屬的一些種可能應歸入棒桿菌屬或節桿菌屬。近年來,仍有不少菌株被定名為短桿菌屬,其中有較重要經濟價值的菌,如輔酶 A產生菌和產多糖物質的菌,後者可望在二次開採石油中套用。
庫特氏菌屬 幼齡菌體為不分枝的規則桿菌,3~7天的老齡菌常由桿菌斷裂而成類球狀細胞;接觸酶陽性;不從碳水化合物產酸;專性好氧。目前正式承認的只有一個種──佐氏庫特氏菌。
微桿菌屬 主要見於乳製品中或乳具上。為具有圓端的小桿菌。目前對此屬的存在與否仍有爭論。